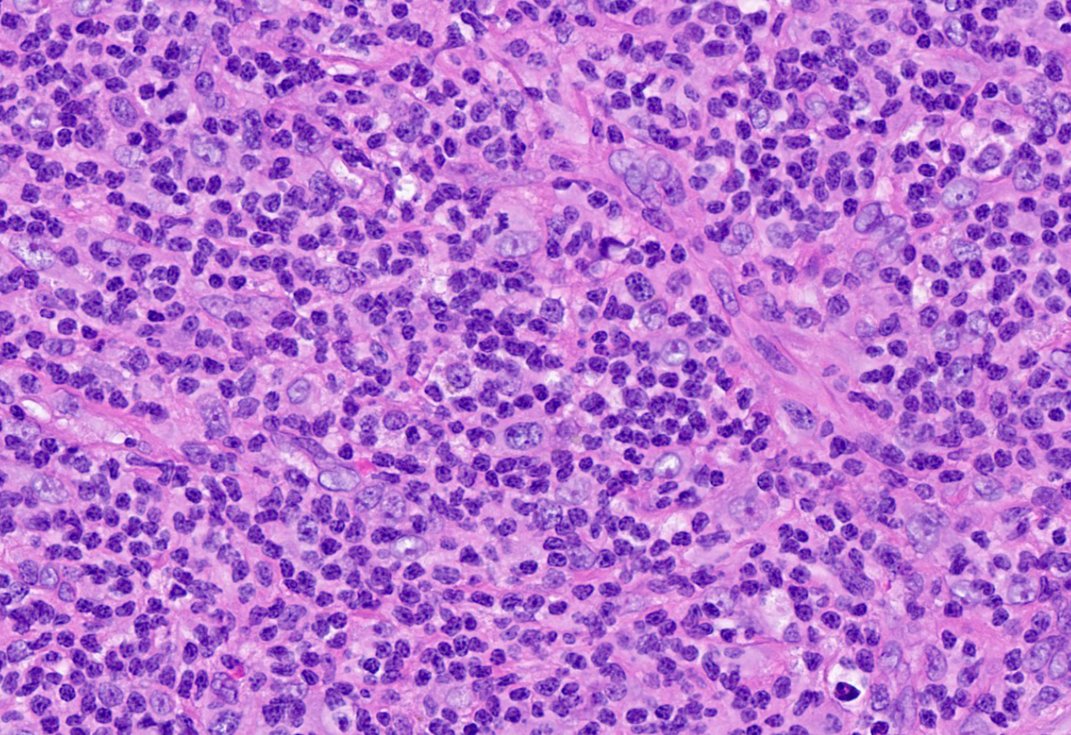
10/The node has arrived! It's effaced. Few atypical cells, mostly small lymphocytes. Is that a high endothelial venule (HEV)?
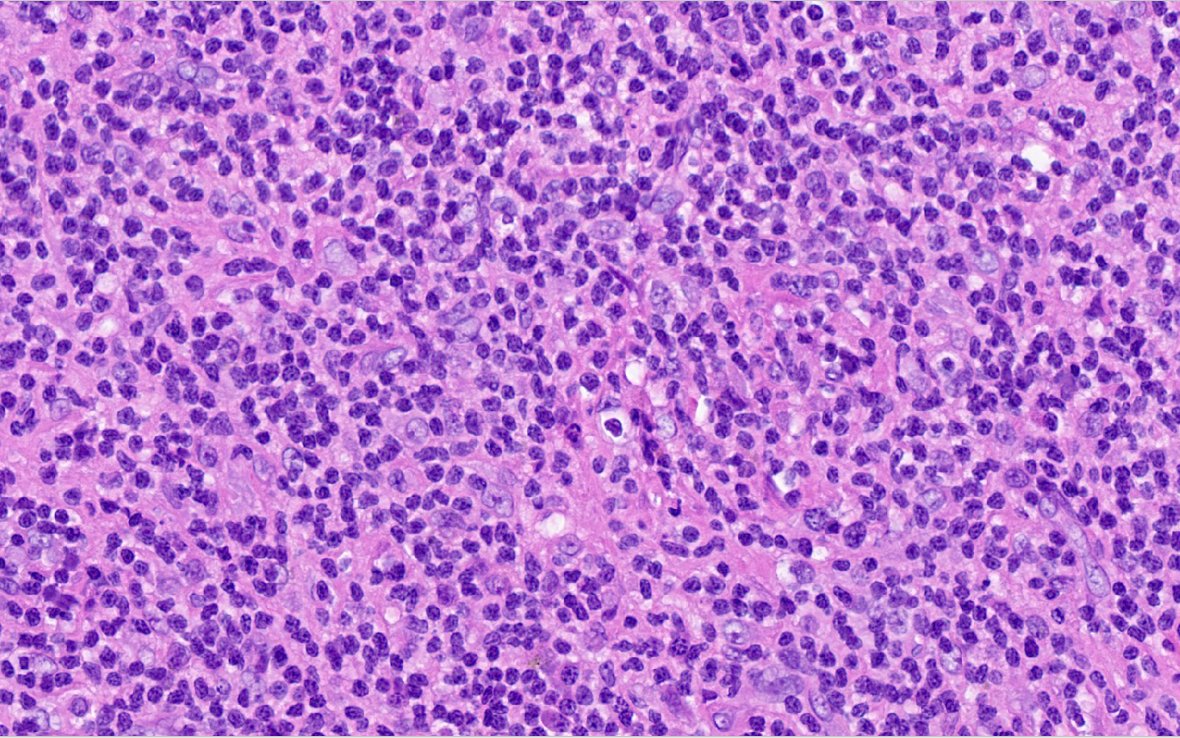
19/Anyone want to go back to the morphology?

Ready for a wild #hemepath #tweetorial? This case blew me away. Lots to unpack, so let's get started:
1/
50-year-old female. No past medical history. Presents with left neck swelling, leukocytosis (~15), thrombocytosis (~600), and elevated LFTs (obstructive picture).
1/
50-year-old female. No past medical history. Presents with left neck swelling, leukocytosis (~15), thrombocytosis (~600), and elevated LFTs (obstructive picture).
2/
PET/CT showed multiple enlarged lymph nodes concerning for a lymphoproliferative disorder. Among these are multiple mildly enlarged LNs in the porta hepatis and gastrohepatic ligament.
PET/CT showed multiple enlarged lymph nodes concerning for a lymphoproliferative disorder. Among these are multiple mildly enlarged LNs in the porta hepatis and gastrohepatic ligament.
3/
Given the lack of obvious liver involvement, a biopsy of the liver was performed, which showed a sinusoidal infiltrate of lymphocytes.
Given the lack of obvious liver involvement, a biopsy of the liver was performed, which showed a sinusoidal infiltrate of lymphocytes.
4/
Without any other information, this pattern may be suggestive of hepatosplenic T-cell lymphoma. What is the typical hepatosplenic T-cell gene rearrangement?
Without any other information, this pattern may be suggestive of hepatosplenic T-cell lymphoma. What is the typical hepatosplenic T-cell gene rearrangement?
5/
Gamma-delta. Hepatosplenic is usually positive for T-cell markers, CD56, and cytotoxic markers (TIA1, granzyme). But...we have diffuse nodal disease, and a nodal biopsy on the way. Let's be patient.
Gamma-delta. Hepatosplenic is usually positive for T-cell markers, CD56, and cytotoxic markers (TIA1, granzyme). But...we have diffuse nodal disease, and a nodal biopsy on the way. Let's be patient.
6/
The peripheral blood flow cytometry is back and only makes things stranger. Note the CD4+ T-cells with aberrant loss of surface CD3 and CD5. The loss of CD3 and CD5 is not characteristic of a particular T-cell neoplasm.
The peripheral blood flow cytometry is back and only makes things stranger. Note the CD4+ T-cells with aberrant loss of surface CD3 and CD5. The loss of CD3 and CD5 is not characteristic of a particular T-cell neoplasm.
7/
Your nodal T-cell lymphoma spidey sense should be tingling. Briefly, this includes:
- Peripheral T-cell lymphoma
- Angioimmunoblastic T-cell lymphoma
- Adult T-cell leukemia/lymphoma
- Anaplastic large cell lymphoma
Your nodal T-cell lymphoma spidey sense should be tingling. Briefly, this includes:
- Peripheral T-cell lymphoma
- Angioimmunoblastic T-cell lymphoma
- Adult T-cell leukemia/lymphoma
- Anaplastic large cell lymphoma
8/
While we're waiting, we can recommend a viral serology. If we're thinking adult T-cell lymphoma, what do we order, what should the peripheral blood cells look like?
While we're waiting, we can recommend a viral serology. If we're thinking adult T-cell lymphoma, what do we order, what should the peripheral blood cells look like?
9/
HTLV-1, flower cell.
Typical boards fodder:
- Endemic to Japan, Caribbean, South America
- Patients present with hypercalcemia
- Infects CD4+ cells
(...also HTLV-3 is HIV)
HTLV-1, flower cell.
Typical boards fodder:
- Endemic to Japan, Caribbean, South America
- Patients present with hypercalcemia
- Infects CD4+ cells
(...also HTLV-3 is HIV)
10/
The node has arrived! It's effaced. Few atypical cells, mostly small lymphocytes. Is that a high endothelial venule (HEV)?
The node has arrived! It's effaced. Few atypical cells, mostly small lymphocytes. Is that a high endothelial venule (HEV)?
11/
Could this be angioimmunoblastic T-cell lymphoma? The background isn't that 'mixed'...what stain(s) would help confirm the diagnosis, where should they be positive?
Could this be angioimmunoblastic T-cell lymphoma? The background isn't that 'mixed'...what stain(s) would help confirm the diagnosis, where should they be positive?
12/
EBV-positive in the background B cells and CD21 to help elucidate the follicular dendritic meshwork. Also, this is a follicular T-cell process, are they present?
EBV-positive in the background B cells and CD21 to help elucidate the follicular dendritic meshwork. Also, this is a follicular T-cell process, are they present?
13/
Everything is negative. Now, just to confirm this is - in fact - a CD4+ T-cell process for those of you doubting we're ever going to get to the bottom of this...
Everything is negative. Now, just to confirm this is - in fact - a CD4+ T-cell process for those of you doubting we're ever going to get to the bottom of this...
16/
Could this be a peripheral T-cell lymphoma? It would be a diagnosis of exclusion given that we don't have classic morphology for ALCL. But what the heck, let's throw on a CD30 and ALK.
Could this be a peripheral T-cell lymphoma? It would be a diagnosis of exclusion given that we don't have classic morphology for ALCL. But what the heck, let's throw on a CD30 and ALK.
20/
Diagnosis: anaplastic large cell lymphoma, small cell variant, ALK+
Diagnosis: anaplastic large cell lymphoma, small cell variant, ALK+
22/
And the concurrent bone marrow that you just received? The one with sprinkled T-cells but nothing really crazy going on? What does ALK look like there?
And the concurrent bone marrow that you just received? The one with sprinkled T-cells but nothing really crazy going on? What does ALK look like there?
23/
Hope you enjoyed this journey through nodal T-cell lymphomas! This one decided to be an overachiever and involve the blood, liver, and bone marrow as well. Crazy case with many learning opportunities.
Hope you enjoyed this journey through nodal T-cell lymphomas! This one decided to be an overachiever and involve the blood, liver, and bone marrow as well. Crazy case with many learning opportunities.
24/
#pathology #PathTwitter #medtwitter #tweetorial #hematopathology #hemepath #oncology #tcell #lymphoma #hematology
#pathology #PathTwitter #medtwitter #tweetorial #hematopathology #hemepath #oncology #tcell #lymphoma #hematology

 Read on Twitter
Read on Twitter